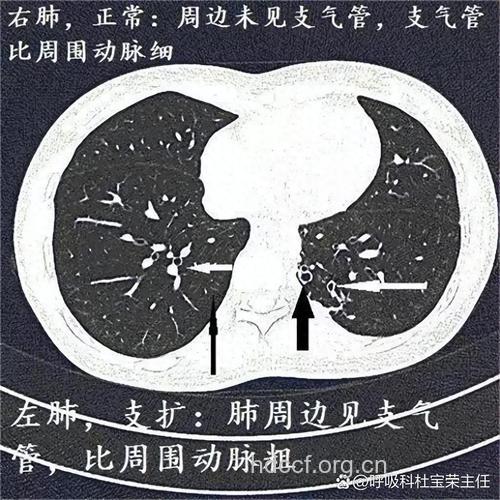
支气管扩张的症状

支气管扩张是一种多见于儿童身上的疾病,大多发病在慢性呼吸道感染,小编就带您学习一下支气管扩张有哪些症状?
支气管扩张病程多呈慢性经过,可发生于任何年龄。起病往往可追溯到幼年患有麻疹、百日咳或流感后肺炎病史,或有肺结核、支气管内膜结核、肺纤维化等病史。症状可能在若干年后才出现。典型症状为慢性咳嗽、咳大量脓痰和反复咯血。咳痰在晨起、傍晚和就寝时最多,每天可达100~400ml,许多病人在其他时间几乎没有咳嗽。咳痰通畅时患者自感轻松;痰液引流不畅,则感胸闷、全身症状亦明显加重。痰液多呈黄绿色脓样,合并厌氧菌感染时可臭味,收集全日痰静置于玻璃瓶中,数小时后可分为3层:上层为泡沫,中层为黄绿色混浊脓液,下层为坏死组织沉淀物。90%患者常有咯血,程度不等,咯血量与病情严重程度、病变范围不一定平行。有些病人,咯血可能是其首发和惟一的主诉,临床上称为“干性支气管扩张”,常见于结核性支气管扩张,病变多在上叶支气管。若反复继发感染,可出现全身毒血症状,病人时有发热、盗汗、乏力、食欲减退、消瘦等。当支气管扩张并发代偿性或阻塞性肺气肿时,患者可有呼吸困难、气急或发绀,晚期可出现肺心病及心肺功能衰竭的表现。
支气管扩张体征无特征性,但肺部任何部位的持续性固定湿啰音可能提示支气管扩张,并发肺气肿、肺心病可有相应的体征。部分病人(1/3)可有杵状指(趾),全身营养不良。
您学会了吗?以上就是支气管扩张比较常见的几种症状,如果您患有此类症状,请您及时到正规医院治疗,以免耽误治疗最佳时机。